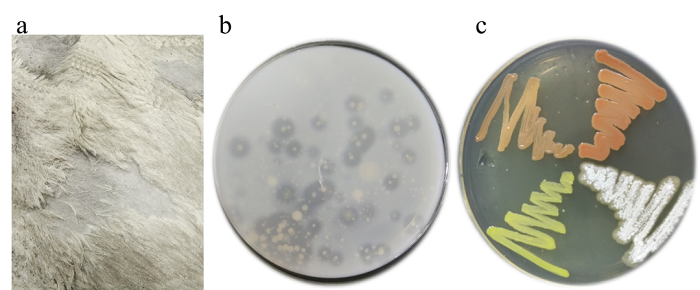

点击数:8952022-12-16 00:00:00 来源: CL编辑部
皮革制造的原材料往往是羊、牛、兔等毛皮动物的皮,含有大量的脂肪和蛋白质,极易受到多种微生物的侵袭,进而影响皮革制品的外观、物化性能等。在制革加工前,通常将大量的NaCl涂抹在动物皮的内外面制成盐湿皮保藏。该方法在抑制普通微生物生长的同时却为嗜(耐)盐菌提供了更好的繁殖条件,且部分微生物会分泌蛋白酶、角蛋白酶、脂肪酶、胶原酶等活性酶,进而导致盐湿皮出现局部脱毛、毛发松动、红斑、粒面损伤等迹象。因此系统研究并深入了解盐湿皮上微生物群落的组成以及时空动态,对进一步完善和开发高质量保藏动物皮的方法具有重要意义。
基于上述背景,四川大学 田永强 教授团队采用基于16S rRNA基因扩增子测序的免培养方法和微生物培养技术,研究了NaCl保藏的羊皮上微生物群落动态与时间的关系。研究发现,盐湿皮内部和表面的微生物群落多样性随着盐腌时间的延长发生着明显变化,微生物由皮外向皮内迁移,且在Sobs、Chao、Ace和Shannon指数下的Alpha多样性整体都呈现出“降、升、降、平”的趋势(图1)。
图1 不同时间点盐湿皮微生物在Chao (a)、Sobs (b)、Ace (c) 和Shannon (d) 指数下的Alpha多样性
此外,盐湿皮上微生物的群落结构(图2)和物种丰度变化结果(图3)表明,盐湿皮微生物的群落组成并不是一成不变的,Acinetobacter、Halomonas、Streptococcus等属微生物会随盐腌时间的延长走向衰亡,并为Natrialba、Haloterrigena等古菌属物种的崛起提供了极大的便利,形成细菌过渡到古菌的演变趋势。

图2 不同时间点盐湿皮微生物样本与物种丰度关联circos弦装图:(a) 域水平;(b) 纲水平;(c) 属水平
图3 盐湿羊皮上典型普通微生物 (a)、中度嗜盐菌 (b) 和极端嗜盐菌 (c) 的相对丰度变化
通过相关性分析(图4),发现盐湿皮上除以Alkalibacillus、Natrialba和Haloterrigena属物种为代表的极端嗜盐菌与时间呈极好的正相关性外,其余大部分微生物都与时间呈负相关性;盐湿皮微生物间存在一定的亲缘关系,且同科分类水平下的物种存在相似的耐、嗜盐性;另外,Veen图分析揭露Salinicola、Luteimonas、Salimicrobium、Ornithinibacillus、Halomonas、Bacillus、Brevundimonas等属菌株在盐湿皮保藏过程中一直都在,且遍布盐湿皮的内外部,推测它们是导致盐湿皮出现红斑、脱毛、烂皮等症状的主力军。
图4 盐湿皮微生物的相关性分析:(a) 盐湿皮微生物与时间的相关性网络图;(b) 盐湿皮上微生物间的系统进化关系;(c) 17组微生物样本中独有和共有细菌的组成
同时,通过分离、培养等手段从盐湿皮上筛选得到45株蛋白酶产生菌(图5),其中所产部分蛋白酶具有脱毛和/或胶原降解活性,进一步说明盐湿皮中的某些耐盐/嗜盐菌是盐腌皮质量下降的原由。同时本研究也发现了几株新的微生物菌种资源,丰富了嗜(耐)盐菌资源库。
Reference
Spatiotemporal dynamics of the microbial diversity on salt-preserved goatskins assessed by culturing and 16S rRNA gene amplicon sequencing
Xiaoguang Li, Keya Sen, Yuqin Zhang, Yongqiang Tian* and Bi Shi
文章链接:
https://doi.org/10.1186/s42825-022-00107-1
期刊简介:
Collagen and Leather,原名Journal of Leather Science and Engineering(纸质刊已启用新名称,网络版将于2023年初启用新名称),是在中国科技期刊国际影响力提升计划高起点新刊项目资助下创办的胶原与皮革领域重要学术期刊。由教育部主管,四川大学主办,Springer合作出版,主编为中国工程院院士 四川大学 石碧 教授和英国北安普顿大学 终身名誉教授Anthony Dale Covington。2019年7月创刊,文章篇均引用率超过7.0(Scopus数据),目前已被DOAJ和Scopus数据库收录,正在申请进入ESCI、EI、中国科技核心期刊等数据库。
期刊主页:
https://jlse.springeropen.com/
微信公众号:Collagen and Leather
长按扫码关注我们